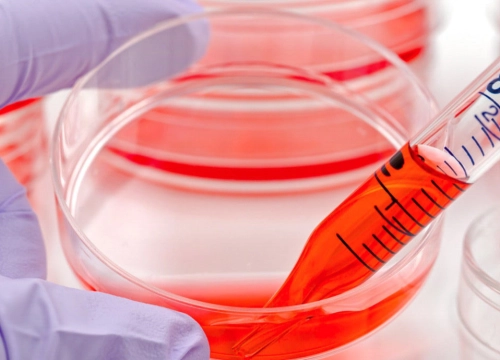
Stem Cell Therapy

Overview Exosome therapy is an advanced regenerative service that utilizes extracellular vesicles derived from biologic sources to support cellular communication and tissue signaling.
LEARN MORE
Overview Platelet-Rich Plasma (PRP) is an autologous biologic therapy derived from a patient’s own blood and processed to concentrate platelets rich in growth factors and signaling proteins.
LEARN MORE
Overview Platelet-Rich Fibrin (PRF) is an advanced form of platelet therapy that utilizes a patient’s own blood to create a fibrin-based scaffold rich in platelets,
LEARN MORE
What is Regenerative Medicine? Regenerative medicine has been defined as the process of replacing or “regenerating”
LEARN MORE
Restore your youth and look years younger with the regenerative power of Cell Therapy.
LEARN MORERegenerative medicine is a multidisciplinary area of medical research focused on understanding how the body repairs and maintains tissues. This field explores scientific approaches that aim to support or stimulate natural biological processes involved in healing. Researchers across the United States — including those serving communities in Long Island, New York — continue to study how regenerative techniques may contribute to future medical advancements.
Stem cells are undifferentiated cells that have the potential to develop into specialized cell types. In research settings, stem cells may be derived from a patient’s own body (autologous sources) or from donor-derived tissues, depending on regulatory standards and study protocols. Not all stem cell–based applications are FDA-approved, and many remain under clinical investigation.
Platelet-rich plasma (PRP) is a biologic product derived from a person’s blood and is studied in various medical specialties. PRP contains concentrated platelets that release growth factors, which researchers believe may play a role in tissue repair mechanisms. PRP applications vary by medical discipline, and outcomes remain the subject of ongoing research and clinical evaluation.
Mesenchymal stem cells (MSCs) are multipotent cells commonly studied for their potential regenerative properties. They may be sourced from bone marrow, adipose (fat) tissue, or other tissues depending on research methodology. Clinical trials continue to evaluate the safety, regulatory status, and effectiveness of MSC-based approaches across multiple medical fields.


Regenerative medicine research spans multiple disciplines, including:
The degree of scientific support varies depending on the specific application being studied.
Researchers are evaluating whether certain regenerative approaches may:
However, safety profiles, effectiveness, and long-term outcomes differ depending on the technique and remain under continued investigation.

Not all regenerative medicine applications are FDA-approved. Some biologic products are approved for specific indications, while many stem cell–based therapies remain investigational. Individuals in Long Island, NY, researching regenerative medicine should verify the regulatory status of any specific treatment with licensed medical professionals.
Reported experiences vary depending on the specific technique used. In clinical research settings, some individuals report temporary soreness or localized discomfort. The type and intensity of side effects depend on the procedure being studied.
Eligibility for regenerative procedures depends on a comprehensive medical evaluation, overall health status, and the specific condition involved. Clinical trials often establish detailed inclusion and exclusion criteria. Individuals should consult qualified healthcare providers to determine appropriate medical options.
Regenerative medicine research explores potential applications in areas such as joint disorders, neurologic conditions, cardiovascular disease, dermatologic concerns, and immune-related disorders. The strength of scientific evidence varies by condition, and many uses remain under clinical investigation.
Stem Cell Bio Therapies provides educational information to Long Island, NY residents about advanced regenerative approaches and their potential effects on the body’s natural healing and overall appearance.
Submit the form below to receive detailed information about stem cell procedures for educational purposes only.